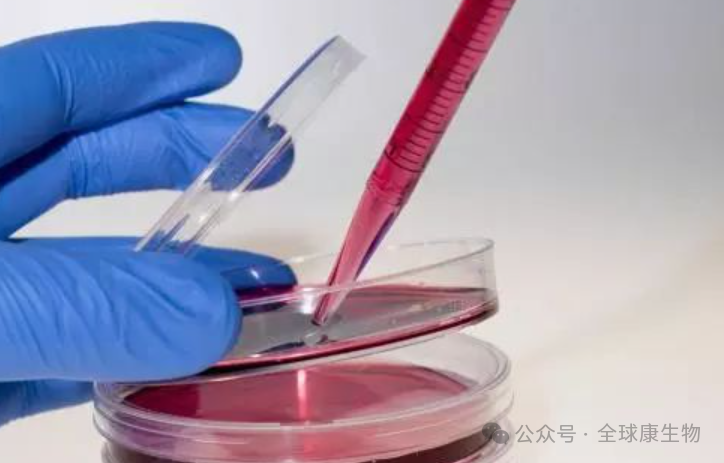

NEWS
-
-

History of Fetal Bovine Serum FBS use in cell culture
Ringer's cell culture-medium, developed by Sydney Ringer in 1882, was an early example of in vitro culture of animal tissue. In the following decades, driven by scientific and technological innovation, early animal cell culture and synthetic media have appeared. The 1940s saw the establishment of cell lines, the birth of basic media, and the development of protein-free media.
2025-01-07
-

How to judge the quality of Fetal Bovine Serum through COA
Fetal bovine serum is a serum obtained from bovine embryos and is commonly used to prepare animal cell culture media. Fetal bovine serum contains various growth factors and has low levels of antibodies.
2024-10-29
-

Contamination types, control and prevention of cell culture
In the process of cell culture, once contamination occurs, researchers usually face great challenges and losses. Cell contamination will not only cause delays in the progress of experiments, affect the output of research results, and may even pose a threat to other cell lines in the entire laboratory. Therefore, it is important to understand and master effective cell pollution treatment methods.
2024-08-01
-

The difference between primary culture and pass culture in cell test
Primary culture and pass-through culture are two basic concepts in cell culture experiments, and there are some differences in the source, culture process and characteristics of cells.
2024-07-25
-

The role and application of high concentration fetal bovine serum in cell culture
Fetal Bovine Serum (FBS) is a commonly used additive in cell culture. It contains abundant growth factors, hormones, proteins and trace elements, which have a significant impact on cell growth and functional maintenance. High concentration fetal bovine serum has its specific role and application in cell culture.
2024-07-16
-

Human breast cancer cell culture
MCF-7 (Michigan Cancer Foundation-7) is a breast cancer cell line originally isolated in 1970 from a 69-year-old white female breast cancer patient, Frances Mallon.
2024-07-04
COMPANY
PRODUCTS
CONTACT
Pre sales team:
Technical support:
After sales complaints:
+86 0335 7166205
info@globekang.com
+86 0335 7166210
service@globekang.com
+86 17703350178
quanqiukang2021@163.com
QUALITY
Tel:+86 0335-7166205
Email:info@globekang.com
Address:No.17 Building, No.2-4 Yongdinghedao,Economic and Technological Development Zones, Qinhuangdao City, Hebei, China
GLOBE KANG Pharmaceutical (Qinhuangdao) Co.,Ltd